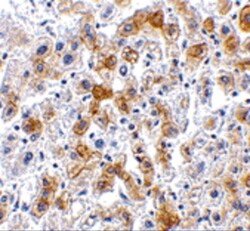

Antibody data
- Antibody Data
- Antigen structure
- References [0]
- Comments [0]
- Validations
- Immunocytochemistry [1]
- Immunohistochemistry [2]
Submit
Validation data
Reference
Comment
Report error
- Product number
- PA5-20339 - Provider product page

- Provider
- Invitrogen Antibodies
- Product name
- SCO2 Polyclonal Antibody
- Antibody type
- Polyclonal
- Antigen
- Synthetic peptide
- Description
- A suggested positive control is human liver tissue lysate. PA5-20339 can be used with blocking peptide PEP-0459.
- Reactivity
- Human
- Host
- Rabbit
- Isotype
- IgG
- Vial size
- 100 μg
- Concentration
- 1 mg/mL
- Storage
- Maintain refrigerated at 2-8°C for up to 3 months. For long term storage store at -20°C
No comments: Submit comment
Supportive validation
- Submitted by
- Invitrogen Antibodies (provider)
- Main image

- Experimental details
- Immunofluorescent analysis of human liver cells using a SCO2 polyclonal antibody (Product # PA5-20339) at a 20 µg/mL dilution.
Supportive validation
- Submitted by
- Invitrogen Antibodies (provider)
- Main image
- Experimental details
- Immunohistochemistry of SCO2 in human liver tissue with SCO2 Polyclonal Antibody (Product # PA5-20339) at 2.5 µg/mL.
- Submitted by
- Invitrogen Antibodies (provider)
- Main image

- Experimental details
- Immunofluorescence of SCO2 in Human Liver tissue with SCO2 Polyclonal Antibody (Product # PA5-20339) at 20 µg/mL.